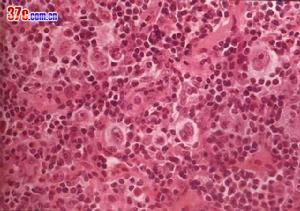
多潘

多潘
多潘名稱
別名 :甲基尿嘧啶氮芥;甲尿嘧啶氮芥 ,多潘
外文名:Chlorethylaminouracil ,Dopan
藥品類別
 多潘
多潘烷化劑抗腫瘤藥
適應症
何杰金病資料
何杰金病
何杰金病何杰金病(hodgkin′sdisease)又名淋巴網狀細胞肉瘤是一種慢性進行性、無痛的淋巴組織腫瘤,其原發瘤多呈離心性分布,起源於一個或一組淋巴結,以原發於頸淋巴結者較多見,逐漸蔓延至鄰近的淋巴結,然後侵犯脾、肝、骨髓和肺等組織。由於發病的部位不同,其臨床表現多種多樣。5歲以前很少發病,5歲以後逐漸增多,青春期發病率明顯增多,15~34歲為高峰。發病者男性多於女性。男女比例在5~11歲為3∶1,19~19歲為1.5∶1。
臨床表現
臨床表現多種多樣,主要決定於病理分型,原發腫瘤的部位和受累器官,疾病的早期或晚期等因素。
最早的表現多是淺表淋巴結呈無痛性進行性腫大,常缺乏全身症狀,進展較慢。約有60%原發於頸淋巴結,原發於鎖骨上、腑下及腹股溝淋巴結的較少見。初起時,淋巴結柔軟,彼此不粘連,無觸痛。後期增大迅速,可粘連成一巨大腫塊。其特點為臨近組織無炎症,不能用以解釋淋巴結腫大的原因。腫大的淋巴結可以引起局部壓迫症狀,如縱隔淋巴結腫大壓迫氣管支氣管,引起乾咳。無原因的腹痛可由於後腹膜淋巴結腫大所致。全身症狀可有低熱,或呈特徵性回歸熱型,即高熱數天后,可有幾天或幾周的無熱期(pel-ebsteinfever)。常有食慾減退、噁心、盜汗和體重減輕,這些症狀當病灶局限時常不出現。皮膚搔癢是成人常見的症狀,在小兒極少見,甚至在全
 何杰金病
何杰金病身廣泛臟器受侵時也不出現。約有1/4的患兒在診斷時已轉移到淋巴結以外的組織,多見於脾、肝、肺或骨及骨髓。肺部浸潤的x線改變多為絨毛狀滲出性改變,與真菌感染不易區別,多有呼吸加快和發熱,甚至出現呼吸功能衰竭。肝臟受累,可出現肝內膽管梗阻症狀,肝臟中度腫大,鞏膜黃染,血清直接與間接膽紅素和鹼性磷酸酶增高。骨髓浸潤則出現中性粒細胞、血小板減少和貧血。消化道受累可發生黏膜潰瘍和消化道出血。淋巴瘤發生在脊髓腔硬膜外,可引起壓迫症狀。此外,亦可出現各種免疫功能紊亂如免疫性溶血,血小板減少或腎病綜合徵。
霍奇金病本身,或由於用化療皆可引致細胞免疫功能低下,此類病兒很易發生繼發感染,約有1/3病兒出現帶狀皰疹,並可擴散侵犯肺組織。隱球菌、組織胸漿菌和白色念珠菌等黴菌感染也是常見的併發症,且病灶比較廣泛。
慢性粒細胞白血病
 白血病
白血病慢性粒細胞白血病,簡稱慢粒,為慢性白血病中最常見一種類型。慢粒起病緩慢,早期多無明顯症狀,往往在體格檢查或其他疾病就診時偶然發現脾腫大或白細胞異常而獲得確診。在我國,慢性白血病中以慢粒最為常見,患者年齡在30-40歲者居多,20歲以下罕見。慢粒在臨床上可分為慢性期,加速期及急變期。病人出現急性白血病的臨床及血液等表現,稱之為慢粒急變。多數患者中數生存期為3-4年。慢粒發生急變後預後極差。
臨床表現
1.起病緩慢,部分病人早期可以沒有任何症狀。2.乏力:低熱、多汗或盜汗,體重減輕。3.最突出體徵為脾腫大,往往為巨脾,肝臟常有中度腫大,淺表淋巴結多不腫大。4.胸骨下部壓痛。5.急變期表現同急性白血病
診斷依據
 白細胞
白細胞1.慢性期:(1)臨床表現:無症狀或有低熱、乏力、多汗、體重減輕等症狀;(2)血象:白細胞計數增高,主要為中性中晚幼和桿狀粒細胞,原始細胞(Ⅰ型+Ⅱ型)≤5-10%,嗜酸粒細胞和嗜鹼粒細胞增多,可有少量有核紅細胞。(3)骨髓象:增生明顯至極度活躍,以粒系增生為主,中、晚幼粒和桿狀核粒細胞增多,原始細胞(Ⅰ型+Ⅱ型)≤10%。(4)染色體:有Ph染色體。(5)CFU-GM培養:集落或集簇較正常明顯增加。
2.加速期:具下列之二者,可考慮為本期。(1)不明原因的發熱、貧血、出血加重和或骨骼疼痛。(2)脾臟進行性腫大。(3)不是因藥物引起的血小板進行性降低或增高。(4)原始細胞(Ⅰ型+Ⅱ型)在血中及/或骨髓中>10%。(5)外周血嗜鹼粒細胞>20%。(6)骨髓中有顯著的膠原纖維增生。(7)出現Ph以外的其他染色體異常。(8)對傳統的抗慢粒藥物治療無效。(9)CFU-GM增殖和分化缺陷,集簇增多,集簇和集落的比值增高。
3.急變期:具下列之一者可診斷為本期。(1)原始細胞(Ⅰ型+Ⅱ型)或原淋+幼淋,或原單+幼單在外周血或骨髓中>=20%。(2)外周血中原始粒+早幼粒細胞>=30%。(3)骨髓中原始粒+早幼粒細胞>=50%。(4)有髓外原始細胞浸潤。(5)CFU-GM培養呈小簇生長或不生長。
治療原則
1.化療;2.干擾素的套用;3.支持療法;4.骨髓移植。
用藥原則
1.對典型慢性期患者以馬里蘭、羥基脲為首選化療藥物,無效則改用或加用其他藥物。2.對加速期和急變期應按急性白血病給予強烈化療。化療同時支持療法。3.對慢粒慢性期患者,有條件者給予干擾素長期治療。4.脾區放射治療現已少用,但巨脾估計不能縮小者,可酌情使用該療法。5.脾切除術不作為常規治療,如有可能發生脾破裂或脾功能亢進伴血小板明顯減少者可考慮切脾。6.有條件者於骨髓完全緩解後行骨髓移植術。
用量用法
口服:8~10mg,每4~6日1次,5~7次為1療程。
規格
片劑:每片1mg、2mg、5mg。
注意事項
1.對骨髓有抑制作用,血小板及白細胞下降明顯,經常要檢查血象觀察其變化。
2.胃腸道反應有噁心、嘔吐及食欲不振等。

